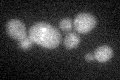
YER001W
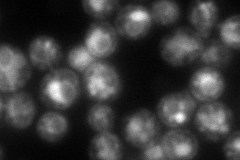
YER001W
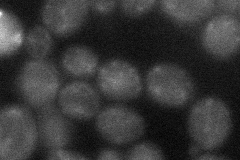
YER001W
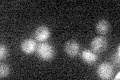
YER001W

View description
Alpha-1,3-mannosyltransferase, integral membrane glycoprotein of the Golgi complex, required for addition of alpha1,3-mannose linkages to N-linked and O-linked oligosaccharides, one of five S. cerevisiae proteins of the MNN1 family
Localization:
Intensity:
Fold change:
Significance:
-
C’ GFP library in SD
punctate19.48 -
N' NOP1pr-GFP in SD

ER,punctate92.5676 -
N' TEF2pr-mCherry in SD
ER,vacuole133.432 -
N' NATIVEpr-GFP in SD

punctate35.6886 -
N' TEF2pr-VC and Cyto-VN in SD
punctate31.8018 -
C’ GFP library in SD+DTT

punctate15.990.82No -
C’ GFP library in SD+H2O2

punctate18.60.95No -
C’ GFP library in Starvation Media
punctate19.621No -
C’ GFP library on the background of Pup2-DaMP

punctate -
C’ GFP library on the background of CCT mutant

punctate17.0860.876666No
